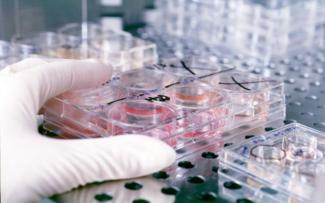

Τους 40 νεκρούς σε 119 κρούσματα έχει φτάσει η επιδημία βουβωνικής πανώλης που πλήττει τη Μαδαγασκάρη, που ξέσπασε στα τέλη Αυγούστου, σύμφωνα με απολογισμό του Παγκόσμιου Οργανισμού Υγείας (ΠΟΥ).
Δυο κρούσματα έχουν εντοπιστεί στην πρωτεύουσα Ανταναναρίνο, με τον ΠΟΥ να προειδοποιεί για κίνδυνο «γρήγορης εξάπλωσης» της ασθένειας στην πυκνοκατοικημένη πόλη, με δεδομένες και τις «αδυναμίες του συστήματος υγείας».
Οι άνθρωποι προσβάλλονται από την πανούκλα λόγω των δαγκωμάτων μολυσμένων ψύλλων, που συνήθως βρίσκονται στο τρίχωμα αρουραίων.
Η κατάσταση περιπλέκεται από το γεγονός ότι οι ψύλλοι στη Μαδαγασκάρη έχουν αναπτύξει υψηλή αντοχή στο εντομοκτόνο deltamethrin, που χρησιμοποιείται ευρέως στη χώρα.
Η ασθένεια αντιμετωπίζεται με αντιβιοτικά αν διαγνωσθεί εγκαίρως.
Ωστόσο, σύμφωνα με το δελτίο του ΠΟΥ, το 2% των κρουσμάτων στη Μαδαγασκάρη οφείλεται στην σπανιότερη πνευμονική μορφή, η οποία μπορεί να σκοτώσει τα θύματα ακόμα και μέσα σε 24 ώρες.
kathimerini.gr